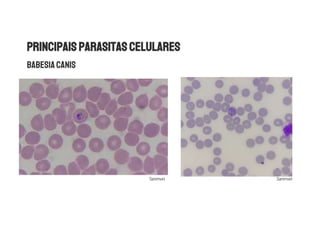
Sanimvet
Sanimvet
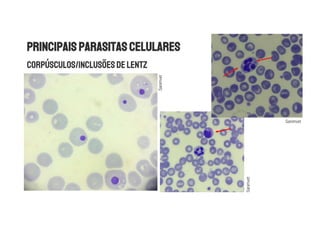
Sanimvet
Sanimvet
Sanimvet

O documento discute a interpretação do hemograma, incluindo a classificação da anemia e a contagem de reticulócitos. Explica como analisar os achados do eritrograma para diagnosticar o tipo e gravidade da anemia e avaliar a capacidade de regeneração da medula óssea. Também lista possíveis causas para cada tipo de anemia com base nos índices hematimétricos.